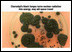

Случайная компания
Сайт: http://choicehotels.com
Тема недели

Петербургский Центр компетенций в сфере туризма и гостеприимства за год обучил почти 2000 специалистов из разных регионов
Международный центр компетенций в сфере туризма и гостеприимства, учрежденный Комитетом по развитию туризма Санкт‑Петербурга
itnews.com.ua

Контактная информация
Адрес: Киев
Телефон: /044/ 493-4930
Сайт: http://itnews.com.ua/
E-Mail: info@itnews.com.ua
Описание
ITnews - украинское интернет-издание, освещающее на русском языке мировые и украинские события в области высоких технологий. Не всегда достаточно времени, что бы отследить все самые интересные новинки в мире информационных технологий, не всегда достаточно времени, что бы понять, насколько тот или иной гаджет хорош собой, насколько его цена соответствует качеству, насколько, скажем, выгоден тот или другой тарифный план. Именно на эти вопросы вы и найдете ответы в этом сообществе. Автор – обозреватель портала www.ITnews.com.ua ставит своей целью не только знакомство с самыми интересными новостями в мире ИТ, но и разъяснить читателями Why is Why в столь экстравагантном мире информационных технологий!!!

Китай заводить Єгипет у свій дроновий клуб
03 декабря 2025 Меморандум AOI та NORINCO щодо спільного виробництва ударного БпЛА Hamza-2 означає, що Каїр переходить від ролі імпортера до співвиробника китайських
В Китаї показали копію американського ударного гвинтокрила Apache
03 декабря 2025 Нові кадри Z-21 показують, що Китай переходить від "експериментів з бойовими гелікоптерами" до формування повноцінного ударного інструменту для війни наЕвропа наращивает рекордные объемы оборонного производства
03 декабря 2025 В отчете Ассоциации аэрокосмической, оборонной и энергетической промышленности Европы (ASD), на который ссылается Bloomberg, говорится, что в 2024 году оборонный сектор ЕС вырос на
Росія озброює Shahed ракетами Р-60
03 декабря 2025 РФ перетворює Shahed на повітряного "мінного загороджувача" – і це важливіше як сигнал про зміну логіки війни, ніж як поява нової "чарівної
На Чорнобильській АЕС знайшли грибок, який "харчується" радіацією
03 декабря 2025 Вчені вважають, що це відкриття здатне кардинально змінити підходи до захисту і будівництва в
Audi зарегистрировала три товарных знака в РФ
03 декабря 2025 Компании одобрили заявки на регистрацию рекламного слогана Vorsprung durch Technik и брендов Allroad и
Стармер: Китай представляет угрозу нацбезопасности Британии
03 декабря 2025 Премьер Британии Стармер назвал Китай угрозой для нацибезопасности страны, но выступил за сотрудничество с
Польща посилила ключовий хаб, через який проходить 95% допомоги Україні
03 декабря 2025 У Польщі завершили розширення злітної смуги в аеропорту Ряшів-Ясьонка — додаткові 700 метрів уже введені в
В Германии украли около 20 тыс. боеприпасов бундесвера из грузовика
03 декабря 2025 Как сообщил Spiegel, водитель гражданского грузовика оставил груз на ночь на незапертой стоянке в промышленной зоне в
Как правильно получить ссуду в Израиле
03 декабря 2025 Получение ссуды (кредита) в Израиле зависит от ее типа, цели кредитования и вашего статуса в стране (резидент, нерезидент или новыйНовости информационных технологий могут по-настоящему заинтересовать тех, кто так или иначе связан с этой сферой деятельности. Менеджеры и директора, it-шники, владельцы бизнеса и просто заинтересованные в получении информации. Тем, для кого словосочетание «информационные технологии» не пустой звук, будет интересно узнать об информационном портале itnews.com.ua.
Кстати, кто заинтересован в публикации, смогут присылать в редакцию этого издания свои материалы и, после рассмотрения, редакция с удовольствием их опубликует, главное, чтобы они были написаны на интересующую всех пользователей этого портала тематику. Неважно, какой будет материал, обзор, статья или новость вшей компании, вы всегда сможете рассчитывать о том, что сотни людей узнают о том, что раньше знали только вы. Такое взаимодействие с редакцией идет на пользу не только журналисту, корреспонденту, копирайтеру или представителю пресс-центра, само интернет-издание становится интереснее для читателя, его формат приобретает более привлекательный вид для читателя.
Сама деятельность интернет-проекта itnews.com.ua заключается в том, что происходит освещение интереснейших событий в сфере IT-технологий на русском языке для жителей Украины.
